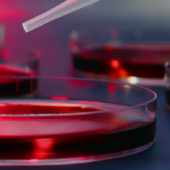
Penatibus et magnis

Lorem ipsum dolor sit amet, consectetur adipiscing elit. Sed blandit massa vel mauris sollicitudin dignissim. Phasellus ultrices tellus eget ipsum ornare molestie scelerisque eros dignissim. Phasellus fringilla hendrerit lectus nec vehicula.
Pellentesque habitant morbi tristique senectus et netus et malesuada fames ac turpis egestas. In faucibus, risus eu volutpat pellentesque, massa felis feugiat velit, nec mattis felis elit a eros.
Cras convallis sodales orci, et pretium sapien egestas quis. Donec tellus leo, scelerisque in facilisis a, laoreet vel quam. Suspendisse arcu nisl, tincidunt a vulputate ac, feugiat vitae leo. Integer hendrerit orci id metus venenatis in luctus.